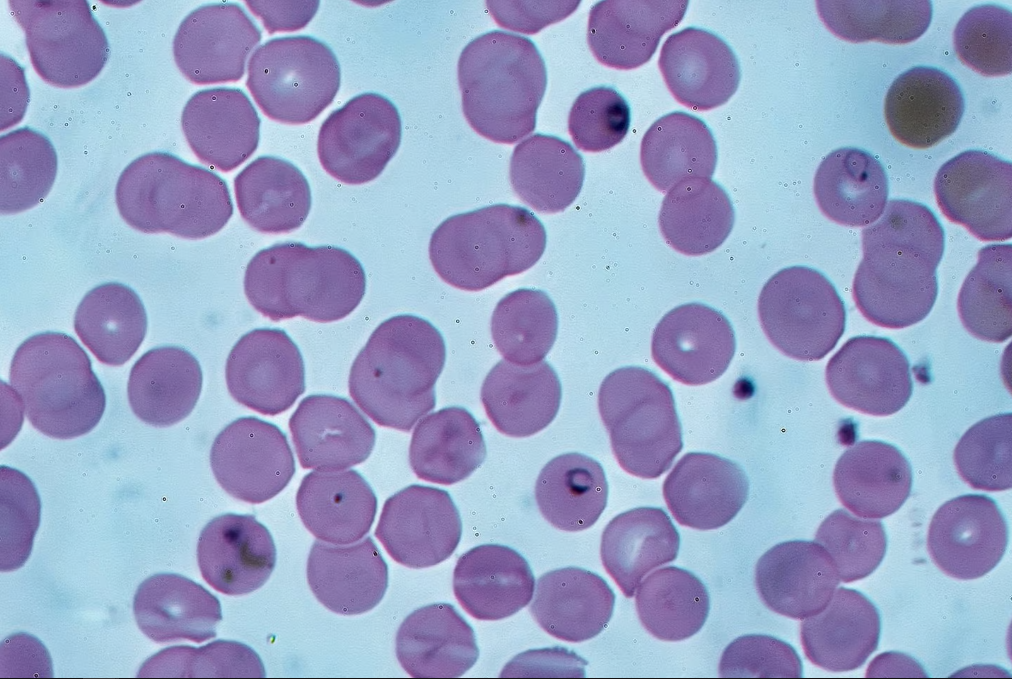
Кольцевые формы P. falciparum в эритроцитах. Доктор Грэм Бирдс , лицензировано в соответствии с лицензией Creative Commons Attribution-Share Alike 4.0 International

Комары отлично справляются с распространением таких болезней, как малярия. Но исследователи показали, что можно «перепрошить роль комара» и распространять вакцины через его укусы. В испытаниях на людях эти вакцины, переносимые комарами, оказались эффективными примерно на 90%.

Это примечательный поворот в . Вместо того, чтобы смотреть на комаров как на проклятие нашего существования, кровососущих паразитов, которые только и делают, что вызывают у нас зуд, исследовательская группа посмотрела на летающий рой как на органическую систему доставки вакцин. Причем систему, которая использует потенциал миллионов лет эволюции как для вакцинации целых популяций, так и для регулярной ревакцинации.
При этом не пришлось даже биохакать комаров.
Причина малярии: одноклеточный паразит
Исследовательская группа из Лондонской школы гигиены и тропической медицины изучала паразита Plasmodium falciparum, который считается самым смертоносным паразитом для человека. Эти одноклеточные простейшие переносятся самками комаров Anopheles, ожидая, когда те найдут жертву для укуса. Паразит прячется в слюнных железах вместе с естественными противовоспалительными и противосвертывающими ферментами комаров.
Когда такой комар кусает человека, то примерно 200 пассажиров P. falciparum попадают в кровоток, и движутся по нему в поисках клеток печени, в которых можно спрятаться, размножиться и трансформироваться. В течение недели каждый из 200 отдельных паразитов выбрасывает в кровоток около 100 000 новых паразитов. И эти новоявленные паразиты начинают активное вторжение, убивают эритроциты и размножаются циклическими волнами. Которые ощущаются организмом через набор симптомов малярии: лихорадка, озноб, истощение, свертываемость крови и ряд других серьезных осложнений.
Малярия по-прежнему остается серьезной проблемой. По оценкам CDC, в 2022 году было зарегистрировано около 249 000 000 случаев заболевания людей, что привело к примерно 608 000 смертям. «Во многих странах, затронутых малярией, — говорится в пояснительной записке CDC, — это основная причина смертности».
Перекуем мечи на орала: модифицированные паразиты становятся вакцинами против себе подобных
Поэтому лондонская группа ученых рассмотрела, как паразит P. falciparum может быть генетически модифицирован, чтобы действовать как вакцина, а не как переносчик болезней. Ученые сконцентрировались на моменте, когда паразит достигает печени человека и начинает размножаться.
Примерно через шесть дней после заражения, модифицированные учеными паразиты GA2 просто перестают развиваться. Они не выпускают второе поколение в кровоток. Вместо этого они выбрасывают целый набор антигенов, которые запускают в иммунной системе человека сильную воспалительную реакцию. Эта реакция будет моментально запускаться в следующий раз, когда обычный паразит, переносящий малярию, попадет в организм.
Тестирование на людях
Каким-то образом команде удалось найти 43 добровольца, желающих протестировать эти новые органические вакцины. На первом этапе тестирования 20 испытуемых подверглись 15 или 50 укусам комаров, переносящих модифицированного паразита GA2. Ни у одного из испытуемых не было признаков заражения на стадии продвижения паразита в крови, что подтверждает безопасность подхода.
Затем, на втором этапе, 23 субъекта должны были трижды, с интервалом в 28 дней, получить 50 укусов либо от обычных комаров, либо от комаров с модифицированными паразитами. Половина комаров была модификацией GA2, половина — другой версией GA1, которые были запрограммированы на остановку развития в печени через один день вместо шести.
Три недели спустя добровольцы снова пришли в клинику, чтобы получить пять укусов от комаров, которые 100% переносят малярию.
Все три субъекта, которые ранее подверглись укусам обычных комаров, заразились малярией, причем 13% тех, кто был привит паразитами, модифицированными GA1, избежали заражения, а среди тех, кто был привит паразитами GA2, 89% сумели избежать заражения.
За исключением зуда, связанного с укусами комаров, побочные эффекты были минимальными.
Пресс-служба исследования
Теперь команда надеется провести гораздо более масштабное исследование, чтобы повторить и подтвердить результаты, и я могу только позавидовать смелости тех людей, которые согласятся на это.
Биомодификация и биохакинг природы. Куда движется мир?
Итак, если более масштабные испытания на людях пройдут успешно, то укусы комаров можно использовать для распространения вакцин. Это не единичный случай, когда плотный симбиоз с чем-то природным служит пользу для человека.
И, возможно, если бы огромное количество насекомых, переносящих GA2, было выпущено на волю в районах, пораженных малярией, их естественный аппетит обеспечил бы целые популяции людей регулярными ревакцинациями в теплые и влажные периоды года, когда риск заражения наиболее высок. И отпала бы необходимость в регулярных миссиях, миллионах шприцов, иголок, заботе о холодильниках и т.д.
Но исследователи не упоминают о подобном плане. Действительно, неясно, куда может привести это исследование. В настоящее время введение паразитов GA2 в насекомых является довольно трудоемким процессом — паразиты культивируются в лаборатории на клетках крови человека, затем этой кровью кормят комаров, и проходит до двух недель, прежде чем комары готовы распространять ее через укусы.
Так что вырастить достаточное количество насекомых для вакцинации целого города было бы не особенно быстро и дешево, и пришлось бы постоянно наращивать популяцию, чтобы конкурировать с дикими комарами. Более того, благодаря особому жизненному циклу паразитов, также маловероятно, что этот метод будет работать для доставки других типов вакцин.
Тем не менее, это крутая идея. Больше материалов на схожую странную тематику, от биотехнологий и рассекреченных документов об НЛО, до нейросетей и вопросов о киберпсихологии вы найдете в нашем сообществе. Подписывайтесь, чтобы не пропустить свежие статьи!
Автор: MisterClever
